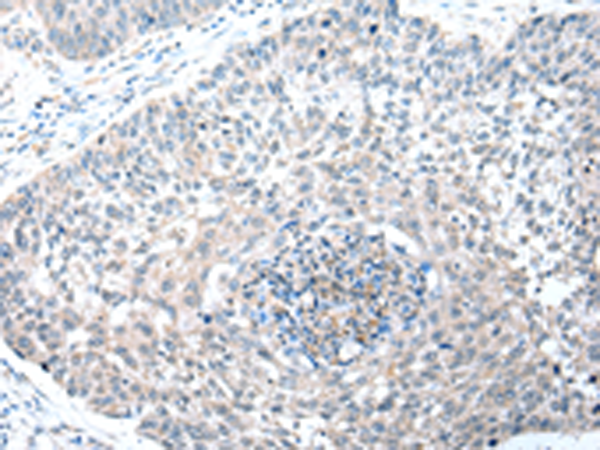

询价单号 点击跳转查看 X



| 编 号 | 规格 | 库存 | 目录价(¥) | 您的价格(¥) | 数 量 |
| D123562-0025 | 25 ul | 现货 | 待询价 | 待询价 | |
| D123562-0100 | 100 ul | 现货 | 待询价 | 待询价 | |
| D123562-0200 | 200 ul | 现货 | 待询价 | 待询价 |
概述
WD-repeats are motifs that are found in a variety of proteins and are characterized by a conserved core of 40-60 amino acids, which commonly form a tertiary propeller structure. While proteins that contain WD-repeats participate in a wide range of cellular functions, they are generally involved in regulatory mechanisms involving signal transduction, apoptosis, transcriptional regulation, cell cycle control. WD repeats serve as sites for protein-protein interaction and some seem to mediate the assembly of protein complexes. WDR41 (WD repeat-containing protein 41) is a 459 amino acid protein that contains six WD repeats. WDR41 is encoded by a gene located on human chromosome 5q13.3.
应用
酶联免疫吸附测定(ELISA),免疫组织化学(IHC)
属性
| 保存缓冲液 | -20°C, pH7.4 PBS, 0.05% NaN3, 40% Glycerol |
| 运输条件 | 2-8°C |
| 靶点 Uniprot 登记号 | Q9HAD4 |
| 靶点基因 ID | 55255 |
| 靶点全称 | WD repeat domain 41 |
| 靶点别名 | MSTP048 |
| 靶点研究领域 | Cell Biology |
| 亚型 | Immunogen-specific rabbit IgG |























 精确搜索
精确搜索 我的草稿
我的草稿
 我的购物车
我的购物车

 精确搜索
精确搜索